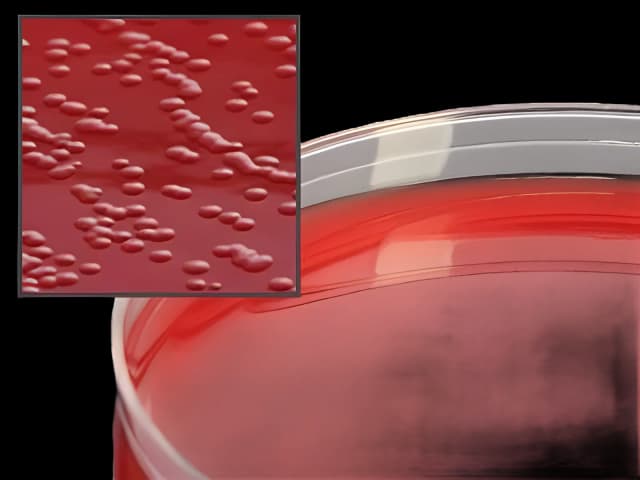
Prepared Media Cefoperazone, Vancomycin, Amphotericin B (Campy CVA) Agar with 5% Sheep Blood Petri Plate Format

Prepared Media Cefoperazone, Vancomycin, Amphotericin B (Campy CVA) Agar with 5% Sheep Blood Petri Plate Format
USAMP#64904899SKU: A40

Product Spotlight
- Ideal for the isolation of Campylobacter from stool cultures in a clinical setting
- To be incubated in a microaerophilic atmosphere at 42° C
- Contains 5% sheep blood from a veterinary supervised, controlled herd of donor animals; blood is guaranteed to be from healthy antibiotic-free animals
- Polystyrene Petri plates feature raised rings for stacking ability and prevents sliding
- Packaged in sleeves of 10 plates in a breathable celluose bag that prevents build-up of condensation and excess moisture